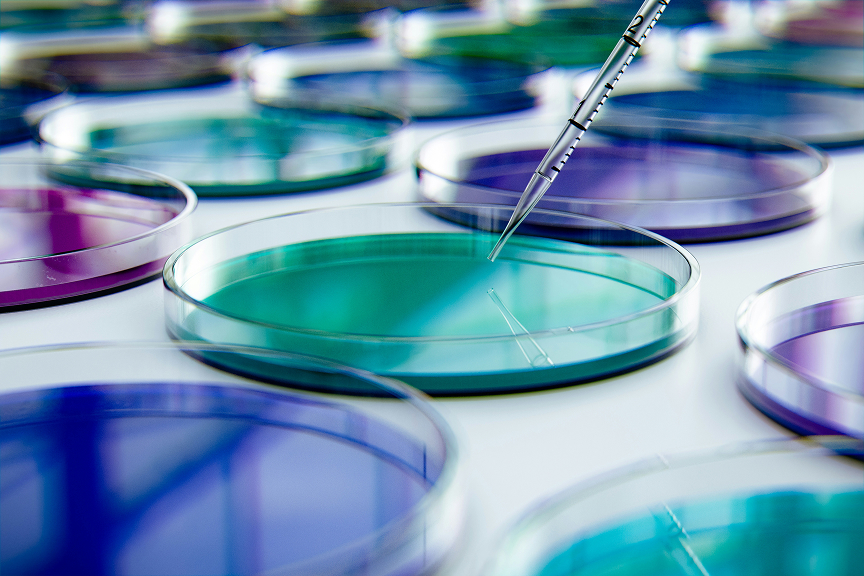
Pipetta da laboratorio per il trasferimento di liquidi in piastre di Petri durante una ricerca clinica

Soluzioni su misura per ogni ruolo
Indipendentemente dal ruolo che ricopri, la traduzione non deve mai rappresentare un ostacolo.
Con Welo Life Sciences, i team Clinical, Regulatory, Safety, Device e Commercial che operano in contesti ad elevata regolamentazione possono contare su un supporto che fa la differenza.
Lavoro in Clinical Operations
Lavoro in Regulatory Affairs
Lavoro in farmacovigilanza e post market surveillance
Lavoro in IFU, etichettatura e grafica (dispositivi medici e IVD)
Lavoro in marketing e comunicazione commerciale
Operazioni cliniche
Sosteniamo il progresso degli studi globali su più mercati, perché le sperimentazioni cliniche non possono essere rimandate.
I team Clinical Operations gestiscono studi complessi e collaborano con sperimentatori, enti regolatori, sponsor e CRO in diversi Paesi. I protocolli si evolvono, vengono introdotti emendamenti e i materiali per i pazienti rimangono sempre aggiornati, accurati e allineati su scala globale.
Anche piccole incongruenze nella documentazione multilingue possono rallentare le approvazioni dei comitati etici, ritardare l’attivazione dei centri e aumentare i rischi in fase di revisione regolatoria.
Nei trial internazionali, la traduzione costituisce solo uno dei passaggi, ma in mancanza di uniformità l’impatto si ripercuote sull’intero studio.
Quando si presenta il rischio linguistico
Il rischio linguistico tende a emergere durante le tappe fondamentali della sperimentazione:
- Ritardi dei comitati etici dovuti a traduzioni incongruenti dei consensi informati
- Conflitti tra versioni derivanti dagli aggiornamenti agli emendamenti del protocollo
- Difficoltà dei pazienti nel comprendere i materiali dello studio tradotti
- Incongruenze terminologiche tra protocolli, siti e documentazione normativa
Il nostro supporto per Clinical Operations
- Portafoglio di servizi diversificato per supportare l’intero ciclo di vita della sperimentazione
- Flussi di traduzione trial clinici ottimizzati per gli studi globali
- Rapidità nella gestione degli emendamenti e nel controllo delle versioni
- Gestione centralizzata della terminologia e verifiche di coerenza abilitate dall’AI sull’intero set documentale
- Documentazione conforme alle normative e idonea alle ispezioni
- Integrazione eTMF, compreso Veeva Vault
- Gestione (e)COA end-to-end e convalida linguistica COA

Affari regolatori
Richieste di autorizzazione che superano i controlli delle autorità. L’accuratezza normativa per noi è importante quanto lo è per gli enti regolatori.
I team Regulatory Affairs operano al punto d’incontro tra rigore scientifico, tempistiche per le richieste di autorizzazione ed evoluzione dei requisiti normativi globali. Coerenza globale, conformità locale: la documentazione rimane allineata tra i mercati e aderente ai requisiti delle autorità regolatorie.
Con l’ampliarsi dei programmi di sviluppo nei mercati internazionali, garantire un allineamento tra le traduzioni delle richieste di autorizzazione, gli aggiornamenti dell’etichettatura e le comunicazioni di tipo normativo diventa una sfida sempre più complessa.
Le incongruenze hanno un impatto a livello procedurale, oltre che linguistico.
Quando si presenta il rischio linguistico
Problemi di carattere linguistico in ambito regulatory sollevano criticità nelle fasi di richiesta di autorizzazione e revisione:
- Documentazione non conforme ai modelli dell’autorità competente
- Errori di traduzione che portano a richieste di chiarimento
- Incoerenza terminologica nei dossier di richiesta di autorizzazione multilingue
- Contenuto dell’etichettatura non corrispondente ai dossier di richiesta di autorizzazione approvati
- Errori di formattazione o localizzazione che causano ritardi nella revisione
Il nostro supporto in ambito Regulatory Affairs
- Traduzioni per ciascuna fase del ciclo di vita delle richieste di autorizzazione
- Traduzione di documenti normativi conformi ai requisiti delle richieste di autorizzazione
- Uniformità multilingue nei dossier e nelle comunicazioni in ambito regulatory
- Controlli di qualità strutturati per soddisfare l’idoneità alle ispezioni
- Flussi di lavoro basati sull’AI per l’uniformità tra le diverse richieste di autorizzazione
Farmacovigilanza e post market surveillance
La velocità è importante, ma l’accuratezza è fondamentale: noi sappiamo garantire entrambe.
I team di farmacovigilanza operano in contesti estremamente sensibili al fattore tempo, con una rapida trasmissione delle informazioni sulla sicurezza tra affiliate, enti regolatori e sistemi di sicurezza globali. È necessario elaborare, controllare, tradurre e inviare le descrizioni dei casi, i reclami relativi ai prodotti e la documentazione di sicurezza entro tempistiche rigorose.
In questo scenario, la traduzione non è semplicemente un’attività documentale; costituisce una parte essenziale del processo di sicurezza.

Quando si presenta il rischio linguistico
- Ritardi nella traduzione delle descrizioni di sicurezza e dei documenti dei casi che impattano le scadenze di segnalazione
- Errata interpretazione delle descrizioni degli eventi avversi
- Incongruenze terminologiche nei report di sicurezza
- Processi manuali e di gestione dei file che rallentano l’elaborazione dei casi
- Mancanza di modelli standardizzati che genera lavoro extra nella documentazione di sicurezza
Il supporto di Welo Life Sciences ai team Safety
- Flussi di lavoro AI che snelliscono il lavoro manuale
- Assistenza scalabile per operazioni di sicurezza a livello globale
- Soluzioni di consegna rapida a 6, 12 e 24 ore
- Supporto multilingue per la traduzione della documentazione di sicurezza
- Controlli sulla coerenza della documentazione di sicurezza supportati dall’AI
- Controlli di qualità in linea con i requisiti di sicurezza globali

IFU, etichettatura e grafica
Documentazione dei dispositivi coerente per ciascun mercato. Un dispositivo, decine di mercati, nessun margine di errore.
I team Medical devices e IVD gestiscono la documentazione del prodotto sottoposta a rigidi regolamenti che deve mantenere allineamento tra mercati, formati di confezionamento e aggiornamenti di prodotto. L’etichettatura, incluse le istruzioni per l’uso, l’identificazione sul dispositivo e la grafica del packaging, deve rispettare i requisiti normativi garantendo al contempo chiarezza per l’utente.
Gli errori multilingue in questo ambito generano rischi di non conformità e interruzioni operative.
Quando si presenta il rischio linguistico
- Traduzioni incongruenti nell’etichettatura e nella documentazione, comprese le IFU
- Aggiornamenti della grafica o del packaging che causano conflitti tra versioni
- Mancata conformità normativa a causa di incongruenze terminologiche o di formattazione
- Ritardi nelle registrazioni globali dei prodotti a causa di incoerenze nella documentazione
Il nostro supporto al team
- Localizzazione in più lingue di IFU, etichettatura e documentazione relativa ai dispositivi
- Flussi di lavoro strutturati a sostegno della compliance normativa globale
- Controllo terminologico per la documentazione dei dispositivi
- Flussi di lavoro integrati per la grafica e il packaging
- Controlli di uniformità basati sull’AI per tutti i contenuti dei dispositivi
Marketing e comunicazione commerciale
Contenuti per il lancio globale che garantiscono coerenza e compliance. La creatività che ispira il marketing unita all’accuratezza Life Sciences.
I team Commercial e Medical Affairs introducono prodotti sul mercato bilanciando strategia di brand, accuratezza scientifica e compliance normativa. Materiali di lancio, comunicazioni mediche e contenuti formativi devono essere sincronizzati tra i mercati e rispettare i quadri normativi locali.
Con l’espansione dei lanci globali, mantenere messaggi multilingue coerenti diventa essenziale per la conformità normativa e la solidità del brand.

Quando si presenta il rischio linguistico
- Rischi di non conformità normativa nei contenuti di marketing localizzati
- Messaggistica incoerente tra i diversi mercati
- Incoerenza terminologica tra ambito medico, regolatorio e commerciale
- Ritardi nei lanci globali dei prodotti a causa di blocchi nella traduzione dei contenuti
- Risorse digitali e multimediali che perdono impatto e chiarezza nei mercati internazionali
Il nostro supporto ai team Marketing e Commercial
- Assistenza multilingue per il lancio di prodotti su scala globale
- Traduzione e transcreation per contenuti di marketing soggetti a compliance
- Gestione strategica della terminologia tra contenuti commerciali e scientifici
- Flussi di lavoro basati sull’AI per campagne globali su larga scala
- Supporto alla produzione creativa e alla localizzazione dei materiali
- Creazione e traduzione di corsi di formazione ed e-learning in più lingue

Supporto sicuro per i tuoi team
Ogni fase del ciclo di vita del prodotto si basa su documentazione multilingue accurata e uniforme. Welo Life Sciences affianca i team Clinical, Regulatory, Safety, Device e Commercial con flussi di lavoro su misura per contesti soggetti a regolamentazione.
